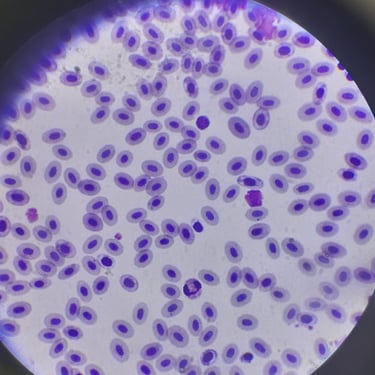

Análisis clínicos
Servicio de laboratorio
Nuestro laboratorio ofrece una gama diversa de pruebas:
Análisis sanguíneo: Permiten evaluar la cantidad y la calidad de células sanguíneas, como glóbulos rojos, glóbulos blancos y plaquetas. Además sirve para realizar pruebas bioquímicas para evaluar la función de órganos como el hígado, el tiroides, los riñones y otros sistemas.
Análisis de orina: Ayuda a detectar posibles infecciones, problemas renales y otros trastornos hormonales.
Análisis coprológico: Para la evaluación de parásitos internos, como lombrices intestinales u otros organismos presentes en las heces.
Citología: Examen microscópico de muestras celulares para identificar células anormales, lo cual es útil en la detección de infecciones y otros trastornos.
Pruebas serológicas: Como la detección de anticuerpos, que son útiles para diagnosticar enfermedades infecciosas como el virus de la inmunodeficiencia felina (FIV), leucemia felina (FeLV) la leishmaniosis, la dirofilariosis, entre otras.